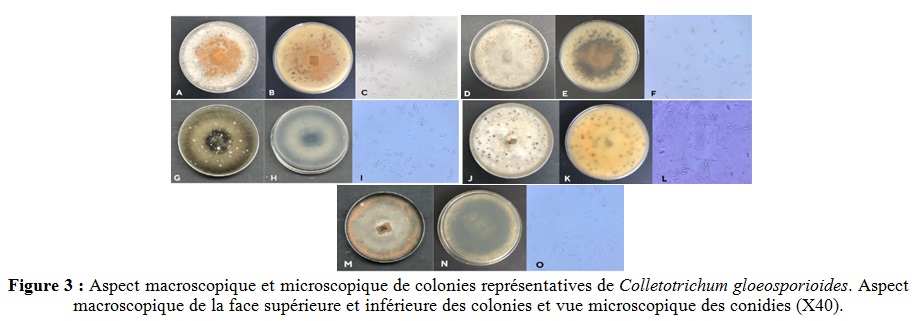

Zineb Belabess1, Meriem Azzouz2, 3, Abdessalem Tahiri3, Rachid Lahlali3
1 INRA CRRA Meknès – 2 INRA CRRA Tanger – 3 ENA Meknès.

Virologie Végétale
URPP – INRA CRRA Meknès
Le dépérissement des agrumes est une menace émergente pour la production agrumicole mondiale (Afzal et al., 2021; Fayyaz et al., 2020; Riolo et al., 2021; Wang et al., 2021). Il entraîne des pertes de rendement, y compris la mort des arbres (Fayyaz et al., 2020). Dans la présente étude, le terme « maladies de dépérissement » désigne des infections variées par leur nature, mais qui présentent généralement une évolution lente, menant souvent à la mort de la plante entière. Le syndrome des agrumes connu sous le nom de « maladie de dépérissement des rameaux et des pousses » est causé par des espèces de Colletotrichum spp. [Sordariomycetes ; Glomerellaceae] (Afzal et al., 2021; Fayyaz et al., 2020; Mayorquin et al., 2019; Ramos et al., 2016; Riolo et al., 2021; Wang et al., 2021). Bien que ces espèces soient reconnues comme agents pathogènes des agrumes responsables des anthracnoses des feuilles et des fruits, leur rôle dans le dépérissement des rameaux et des pousses est devenu plus proéminent récemment (Mayorquin et al., 2019). Par ailleurs, la maladie de dépérissement des rameaux et des pousses d’agrumes est désormais considérée comme un nouveau syndrome dans la région méditerranéenne (Riolo et al., 2021). Le dépérissement des arbres d’agrumes peut également être causé par des champignons du genre Alternaria [Pleosporales ; Pleosporaceae] (Alwan et Mohemed, 2021) et par des espèces de la famille des Botryosphaeriaceae (Berraf-tebbal et al., 2020). Au Maroc, nos visites régulières dans les vergers agrumicoles de la zone de Berkane et du Gharb ont permis d’observer fréquemment des symptômes de dépérissement. Les échantillons collectés ont réagi négativement aux tests de détection de certaines maladies de dépérissement d’origine virale (comme la tristeza et la psorose) et bactérienne (notamment le stubborn) (Belabess et al., 2020). Pour faire face à cette situation, le développement de stratégies de contrôle des agents responsables de ce dépérissement est crucial pour garantir une production agrumicole durable. L’efficacité de ces stratégies repose sur une bonne compréhension de l’écologie et de l’épidémiologie des agents phytopathogènes impliqués. C’est dans ce contexte que cette étude utilise diverses méthodes microbiologiques pour identifier les champignons potentiellement associés au dépérissement observé dans certaines plantations agrumicoles des périmètres du Gharb et du Tadla.
Collecte, identification et évaluation pathologique des champignons associés aux symptômes de dépérissement des agrumes
Des échantillons de rameaux (1350) et de feuilles (400) provenant d’arbres symptomatiques (Figure 1) ont été collectés dans deux des principaux périmètres de production des agrumes au Maroc, à savoir le Gharb et le Tadla. Tous les échantillons ont été soumis à des techniques d’isolement, de repiquage et de purification des colonies fongiques potentiellement associées aux symptômes observés sur le terrain. L’identification des champignons a été réalisée à partir d’une caractérisation morphologique (macroscopique et microscopique) et moléculaire par PCR, avec séquençage de la région interne transcrite (ITS). Enfin, des tests de pathogénicité ont été réalisés pour vérifier les postulats de Koch concernant les champignons identifiés. Ces évaluations ont été menées conformément à la méthodologie établie par Diogo et al. (2010) pour déterminer la capacité de ces isolats à induire des symptômes pathologiques sur les rameaux du bigaradier.
Le dépérissement des agrumes est une menace émergente pour la production agrumicole mondiale (Afzal et al., 2021; Fayyaz et al., 2020; Riolo et al., 2021; Wang et al., 2021). Il entraîne des pertes de rendement, y compris la mort des arbres (Fayyaz et al., 2020). Dans la présente étude, le terme « maladies de dépérissement » désigne des infections variées par leur nature, mais qui présentent généralement une évolution lente, menant souvent à la mort de la plante entière. Le syndrome des agrumes connu sous le nom de « maladie de dépérissement des rameaux et des pousses » est causé par des espèces de Colletotrichum spp. [Sordariomycetes ; Glomerellaceae] (Afzal et al., 2021; Fayyaz et al., 2020; Mayorquin et al., 2019; Ramos et al., 2016; Riolo et al., 2021; Wang et al., 2021). Bien que ces espèces soient reconnues comme agents pathogènes des agrumes responsables des anthracnoses des feuilles et des fruits, leur rôle dans le dépérissement des rameaux et des pousses est devenu plus proéminent récemment (Mayorquin et al., 2019). Par ailleurs, la maladie de dépérissement des rameaux et des pousses d’agrumes est désormais considérée comme un nouveau syndrome dans la région méditerranéenne (Riolo et al., 2021). Le dépérissement des arbres d’agrumes peut également être causé par des champignons du genre Alternaria [Pleosporales ; Pleosporaceae] (Alwan et Mohemed, 2021) et par des espèces de la famille des Botryosphaeriaceae (Berraf-tebbal et al., 2020). Au Maroc, nos visites régulières dans les vergers agrumicoles de la zone de Berkane et du Gharb ont permis d’observer fréquemment des symptômes de dépérissement. Les échantillons collectés ont réagi négativement aux tests de détection de certaines maladies de dépérissement d’origine virale (comme la tristeza et la psorose) et bactérienne (notamment le stubborn) (Belabess et al., 2020). Pour faire face à cette situation, le développement de stratégies de contrôle des agents responsables de ce dépérissement est crucial pour garantir une production agrumicole durable. L’efficacité de ces stratégies repose sur une bonne compréhension de l’écologie et de l’épidémiologie des agents phytopathogènes impliqués. C’est dans ce contexte que cette étude utilise diverses méthodes microbiologiques pour identifier les champignons potentiellement associés au dépérissement observé dans certaines plantations agrumicoles des périmètres du Gharb et du Tadla.

Identification et prévalence des espèces fongiques dans les rameaux et feuilles d’agrumes
Parmi les principaux genres de champignons identifiés, Colletotrichum (40,8 %) est le plus prévalent, suivi d’Alternaria (14,3 %) et de Fusarium (12,2 %). Diaporthe et Dothiorella (4 % chacun), ainsi que Diplodia et Stemphylium (2 % chacun), sont également présents. Les autres isolats (20,4 %) appartiennent à des genres non identifiés.

Les espèces de Colletotrichum (notamment C. boninense, C. catinaense, C. gloeosporioides, C. karsti, C. phyllanthi, C. cymbidiicola, C. fructicola et C. petchii) se sont révélées être les plus fréquemment observées dans les 35 vergers étudiés. Ces résultats sont cohérents avec ceux de Wang et al. (2021), qui ont constaté que Colletotrichum spp. était le genre le plus fréquemment isolé à partir d’agrumes malades. Nous avons également identifié des espèces d’Alternaria (A. alstroemeriae, A. alternata, A. arborescens, A. tenuissima), de Fusarium (F. equiseti, F. longifundum, F. oxysporum), de Diaporthe (D. citri), de Diplodia (D. seriata), ainsi que de Stemphylium (S. amaranthi) et Dothiorella (D. viticola) (Figures 3-4).

Évaluation de la pathogénicité des isolats phytopathogènes sur agrumes
Dans cette étude, un total de 3 isolats potentiellement pathogènes provenant des feuilles et de 15 isolats des rameaux ont été soigneusement évalués pour leur pathogénicité. Les résultats montrent que toutes les espèces testées sont phytopathogènes, provoquant des dommages visibles sur les rameaux et les feuilles inoculés (Figure 5). Tous les isolats se sont révélés pathogènes, D. citri étant l’espèce la plus virulente. Les tests de pathogénicité montrent les effets néfastes des isolats pathogènes provenant des deux régions étudiées, entraînant des lésions nécrotiques de différentes tailles sur les jeunes rameaux de bigaradier âgés d’un an, ainsi qu’un jaunissement prononcé des nervures et l’enroulement des feuilles saines. Ces observations confirment la sévérité des isolats analysés et leur capacité à causer des dommages significatifs aux rameaux et feuilles d’agrumes.

Conclusions et perspectives
Cette étude constitue la première identification exhaustive des espèces fongiques émergentes dans les zones agrumicoles du Gharb et du Tadla. Bien que les résultats soient préliminaires, ils ouvrent la voie à de futures recherches. Il serait pertinent de compléter l’identification des isolats fongiques rapportés dans cette étude et d’évaluer leur pathogénicité. Par ailleurs, il serait envisageable de sélectionner des variétés d’agrumes résistantes ou tolérantes aux champignons pathogènes isolés, afin de réduire la vulnérabilité des cultures.
Références consultées
Afzal, M.U., Khan, S.A., Javid, N., Malik, A.U., 2021. Synergism of citrus nematode (Tylenchulus semipenetrans Cobb.) and Colletotrichum gloeosporioides plays a major role in citrus dieback. Pakistan J. Agric. Sci. 58, 1291–1299. https://doi.org/10.21162/PAKJAS/21.399
Alwan, S.L., Mohemed, S.A., 2021. Molecular Diagnosis of Alternaria spp . Causing Citrus Dieback in Central Iraq. Ann. Rom. Soc. Cell Biol. 25, 10082–10093.
Belabess, Z., Afechtal, M., Benyazid, J., Sagouti, T., Rhallabi, N., 2020. Prévalence des phytovirus associés aux agrumes dans la région de Berkane. African Mediterr. Agric. Journal-Al Awamia 129, 144–160.
Berraf-tebbal, A., Mahamedi, A.E., Aigoun-mouhous, W., Spetik, M., Cechova, J., Pokluda, R., Baranek, M., Eichmeier, A., Alves, A., 2020. Lasiodiplodia mitidjana sp. nov. and other Botryosphaeriaceae species causing branch canker and dieback of Citrus sinensis in Algeria. PLoS One 15, e0232448. https://doi.org/10.1371/journal.pone.0232448
Diogo, E.L.F., Santos, J.M., Phillips, A.J.L., 2010. Phylogeny, morphology and pathogenicity of Diaporthe and Phomopsis species on almond in Portugal. Fungal Divers. 44, 107–115. https://doi.org/10.1007/s13225-010-0057-x
Fayyaz, A., Sahi, S.T., Nawaz-ul-Reliman, M.S., Amrao, L., 2020. Molecular Characterization of Fungal Pathogens Associated with Citrus Molecular Characterization of Fungal Pathogens Associated with Citrus Withertip / Dieback from Major Citrus Growing Areas of Punjab , Pakistan. Int. J. Agric. Biol. 23, 1165–1170. https://doi.org/10.17957/IJAB/15.1400
Mayorquin, J.S., Nouri, M.T., Peacock, B.B., Trouillas, F.P., Douhan, G.W., 2019. Identification, Pathogenicity, and Spore Trapping of Colletotrichum karstii Associated with Twig and Shoot Dieback of Clementine Mandarin and Navel Orange in California. Plant Dis. 103, 1464–1473. https://doi.org/10.1094/PDIS-08-18-1425-RE
Ramos, A.P., Talhinhas, P., Sreenivasaprasad, S., Oliveira, H., 2016. Characterization of Colletotrichum gloeosporioides, as the main causal agent of citrus anthracnose, and C . karstii as species preferentially associated with lemon twig dieback in Portugal. Phytoparasitica 44, 549–561. https://doi.org/10.1007/s12600-016-0537-y
Riolo, M., Aloi, F., Pane, A., Cara, M., Cacciola, S.O., 2021. Twig and Shoot Dieback of Citrus , a New Disease Caused by Colletotrichum Species. Cells 10, 1–23. https://doi.org/https://doi.org/10.3390/cells10020449
Wang, W., de Silva, D.D., Moslemi, A., Edwards, J., Ades, P.K., Crous, P.W., Taylor, P.W.J., 2021. Colletotrichum Species Causing Anthracnose of Citrus in Australia. J. Fungi 7, 1–24. https://doi.org/https://doi.org/10.3390/jof7010047.

